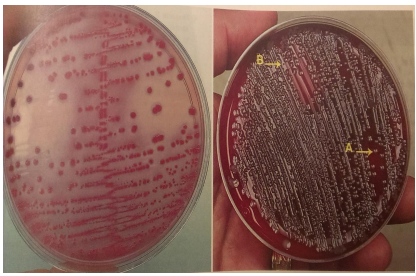
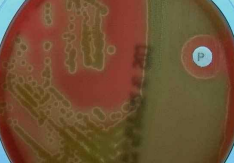
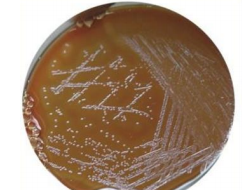
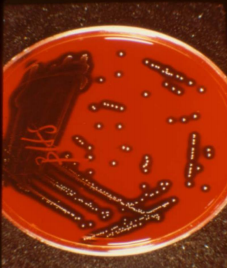
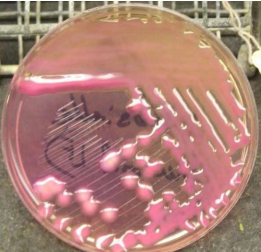
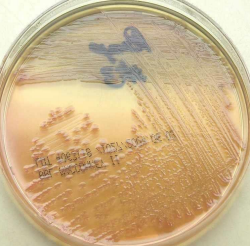
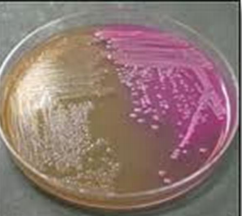
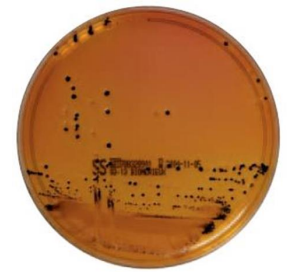
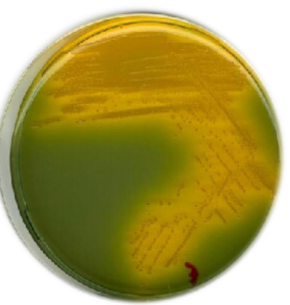
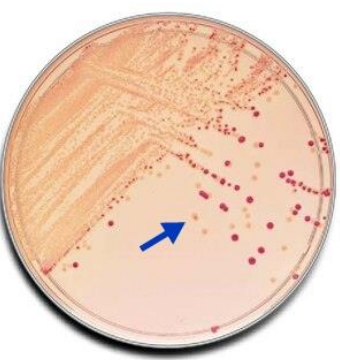
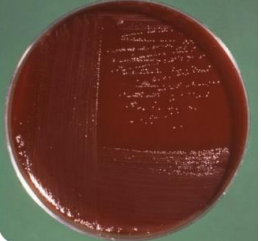

Pediatric Urine Collector
Name this type of culture
Which specimen is cultivated?
What bacteria is cultivated
Urine Quantitative Culture
Urine
E.Coli
Is this sputum sample acceptable? And why?

Unacceptable Sputum
Sample: Predominant epithelial cells vs very few pus cells = Salivary sample
Is this sputum sample acceptable? And why?

Acceptable Sputum Sample
Predominant Pus cells
Mention organism
Stain used

Streptococcus pneumoniae
Gram stain

Staphylococci in purulent sputum
Name the organism
Mention one infection caused by this organism

Klebsiella pneumoniae
Pneumonia
S. pneumoniae
Mention the name of the medium, and the organism growing on it
Chocolate agar
H. influenzae
S. aureus
Klebseilla spp.
Pseudomonas spp.

Antibiotic Susceptibility testing

Hemocytometer for white cell count in effusions

Wet mount preparation

Rectal swab for microbiological examination in infants and small children

Examination of stools for leucocytes

Rotavirus antigen test
Lactose fermenting (pink) and non-fermenting (pale) colonies on MacConkey’s agar
Mention the medium and the growing organism
S-S agar
Salmonella
V. Cholerae on TCBS agar
E. coli on Sorbitol MacConkey agar
Campylobacter spp. on Skirrow’s blood agar

Collection of urine sample from the built in urine catheter port


